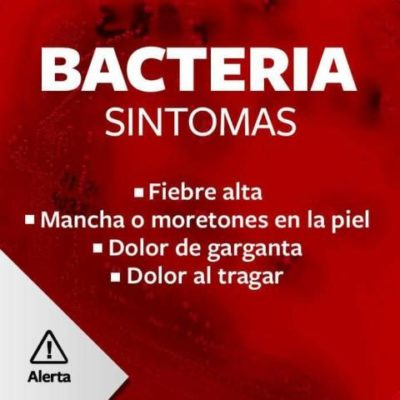

Actualidad
-
5 detenidos al desbaratar un bunker narco en Oberá
En un procedimiento realizado por la división Toxicomanía se incautó 396 gramos de marihuana, y seis plantines de la misma sustancia. A la vez ... -
Imágenes de la noche de reinas en la Fiesta del Inmigrante
La galería de fotos muestra lo que fue la noche elección de reinas de la Fiesta Nacional del Inmigrante, dónde la representante de la ... -
#FiestadelInmigrante: la Reina es de los Países Árabes
La representante de la Colectividad de los Países Árabes, Dahiana Machado Sabbagh, es la nueva Reina Nacional del Inmigrante, en esta edición XXXIX, está ... -
#FiestadelInmigrante: Aquí mira las 15 candidatas
Esta noche la XXXIX edición de la Fiesta Nacional del Inmigrante se viste de gala, porque será la noche elección de Reina y ... -
Aldeas Infantiles SOS en alerta y preocupación por recorte presupuestario
Desde Aldeas Infantiles SOS emitieron un comunicado en la cual expresan su preocupación por la reducción del presupuesto de la Secretaría Nacional de Niñez Adolescencia y ... -
En dos días se duplicó la atención en guardia del Samic
El temor a la bacteria Streptococcus, hizo que el Hospital de Oberá se haya saturado en la atención en guardia y principalmente en el ... -
Muestra de Dibujo en el Museo de la Facultad de Arte y Diseño
El artista Mauro Koliva, graduado de la Facultad de Arte y Diseño (FAyD), estuvo en la ciudad de Oberá el pasado miércoles 5 de septiembre inaugurando ... -
Noche Brasileña hoy en el Parque de las Naciones
La XXXIX edición de la Fiesta Nacional del Inmigrante tendrá para hoy a la “Noche Brasileña” con las actuaciones estelares de San Marino y ... -
Estreno de Los vagos y debate abierto en Oberá
El viernes 14 de septiembre se estrena la película Los vagos en el Espacio INCAA Oberá. La ópera prima del misionero Gustavo Biazzi tuvo ... -
#FiestadelInmigrante: Emoción y buena música en la sexta noche
Pasó el sexto día de la XXXIX Fiesta del Inmigrante y se sigue viviendo muchas emociones, como fue la segunda presentación de las candidatas ...